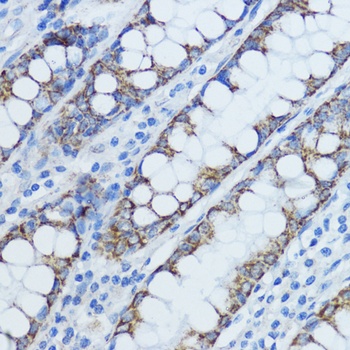
产品细节图片2
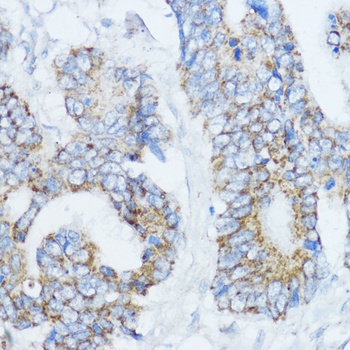
产品细节图片3
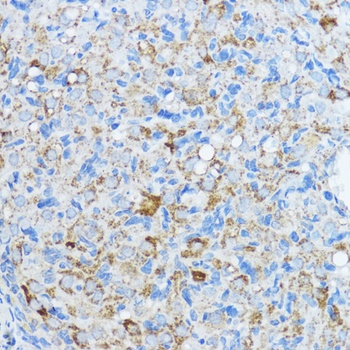
产品细节图片5

相关产品推荐更多 >
万千商家帮你免费找货
0 人在求购买到急需产品
- 详细信息
- 文献和实验
- 技术资料
- 抗体名:
Aromatase Antibody抗体
- 抗体英文名:
Aromatase Antibody
- 靶点:
CYP19A1
- 浓度:
batch dependent
- 应用范围:
IF, IHC, WB
- 适应物种:
Human, Mouse, Rat
- 保质期:
6-12个月
- 抗原来源:
详询
- 目录编号:
orb1260791
- 级别:
科研级
- 库存:
88
- 供应商:
biorbyt
- 标记物:
Unconjugated
- 克隆性:
Polyclonal
- 形态:
Liquid
- 亚型:
IgG
- 免疫原:
Recombinant fusion protein containing a sequence corresponding to amino acids 1-180 of human Aromatase (NP_000094.2).
- 规格:
100 ul
别名:CYP19A1, cytochrome P450, family 19, subfamily A, polypeptide 1, ARO, ARO1, CPV1, CYAR, CYP19, MGC104309, P-450AROM, aromataseN: cytochrome P450, subfamily XIX (aromatization of androgens), estrogen synthetase, flavoprotein-linked monooxygenase, microsomal monooxygenase
免疫原:Recombinant fusion protein containing a sequence corresponding to amino acids 1-180 of human Aromatase (NP_000094.2).
分子量:Observed: 48kDa
应用注释:WB: 1:1000 - 1:2000IHC: 1:50 - 1:200IF: 1:50 - 1:200
防腐剂:Liquid
纯化:Affinity 纯化
保存说明:Maintain refrigerated at 2-8°C for up to 2 weeks. For long term storage store at -20°C in small aliquots to prevent freeze-thaw cycles.
UniProt ID:P11511
Note:For research use only.

风险提示:丁香通仅作为第三方平台,为商家信息发布提供平台空间。用户咨询产品时请注意保护个人信息及财产安全,合理判断,谨慎选购商品,商家和用户对交易行为负责。对于医疗器械类产品,请先查证核实企业经营资质和医疗器械产品注册证情况。
 文献和实验
文献和实验存在于胎盘、马睾丸等微粒体部分,使△4 -3- 氧甾醇的 A 环芳构化,变成酚型酶。开始是 19 位的甲基由 19- 羟化酶进行二次羟化成为二羟化物,接着脱水形成 19- 氧代化物,然后,在 10 位与 19 位之间切断的同时失去 1 位与 2 位的氢而成为醌,烯醇化后生成酚。因此,此系统由 19- 羟化酶与 C 10 -C 19 裂解酶构成,均需要分子态氧与 NADPH 。
Efficient Expression of Human Aromatase (CYP19) in E. coli
Human aromatase (CYP19, P450arom) is responsible for the conversion of androgens to estrogens. In addition to the estrogen biosynthesis in gonads and adrenals in a classical endocrine manner, this enzyme is widely expressed in various tissues
Estrogen-Deficient Mouse Models in the Study of Brain Injury and Disease
of testosterone and androstenedione to 17β-estradiol and estrone, respectively. Aromatization is catalyzed by the P450 aromatase monooxygenase enzyme complex (P450 aromatase, P450arom, CYP19; (5)). In premenopausal women, estrogens are predominantly formed
 技术资料
技术资料暂无技术资料 索取技术资料










